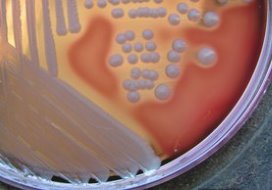

Het risico op een postoperatieve infectie met Staphylococcus aureus in het ziekenhuis kan met 60% omlaag door screening bij opname.
Dat publiceren onderzoekers van de afdeling Medische Microbiologie en Infectieziekten van het Erasmus MC vandaag, vrijdag 8 januari, in het wetenschappelijk tijdschrift The New England Journal of Medicine. De resultaten betekenen een doorbraak in de preventie van wondinfecties na operaties.
Controleren op ziekenhuisinfectie
De onderzoekers tonen aan dat het risico op een ziekenhuisinfectie met Staphylococcus aureus met 60% verlaagd kan worden. Dit resultaat wordt bereikt door patiënten bij opname te controleren op neusdragerschap met de bacterie Staphylococcus aureus en ze direct te behandelen voor hun dragerschap als de bacterie is gevonden.
Bloedbaaninfecties bij intraveneuze katheters
Een op de drie mensen draagt van nature Staphylococcus aureus bij zich in de neus en op de huid. De bacterie veroorzaakt tien tot vijftien procent van alle nosocomiale infecties. Dat zijn ongeveer vijftien- à twintigduizend infecties per jaar in Nederlandse ziekenhuizen. Dit betreft voornamelijk wondinfecties na operatie en bloedbaaninfecties bij intraveneuze katheters. Het tijdelijk weghalen van deze bacterie op een tijdstip dat er een verhoogde kans is op S.aureus infecties, vooral tijdens een ziekenhuisopname, beschermt deze patiënten tegen ‘zelf-infectie’.
Antibioticazalf in de neus
In totaal werden 917 S.aureus neusdragers opgespoord en in het onderzoek betrokken. Zij werden behandeld met een antibioticazalf in de neus en gewassen met een desinfecterende zeep, of zij kregen een placebo voor beide middelen. Het bleek dat in de groep die met de werkzame middelen was behandeld het risico op ziekenhuisinfecties met S. aureus met 60% afnam. Het preventieve effect was het sterkst bij postoperatieve wondinfecties met S. aureus. Met name de ernstigste vormen van S.aureus wondinfecties werden voorkomen met deze methode. Bij die vormen werd een reductie van 80% gehaald.
Duizenden ziekenhusinfecties voorkomen
Universele screening en eliminatie van S.aureus dragerschap bij opname van patiënten in het ziekenhuis, vooral als zij risicovolle ingrepen moeten ondergaan, zal duizenden ziekenhuisinfecties met deze bacteriesoort kunnen voorkomen, zo meldt het Erasmus MC. De studie is een samenwerking met het Amphia Ziekenhuis te Breda, het UMC Utrecht, het VuMC Amsterdam en het Canisius-Wilhelmina Ziekenhuis/St. Maartenskliniek in Nijmegen.
Door: redactie Nursing
Geef je reactie
Om te kunnen reageren moet je inlogd zijn. Inloggen Ik heb nog geen account